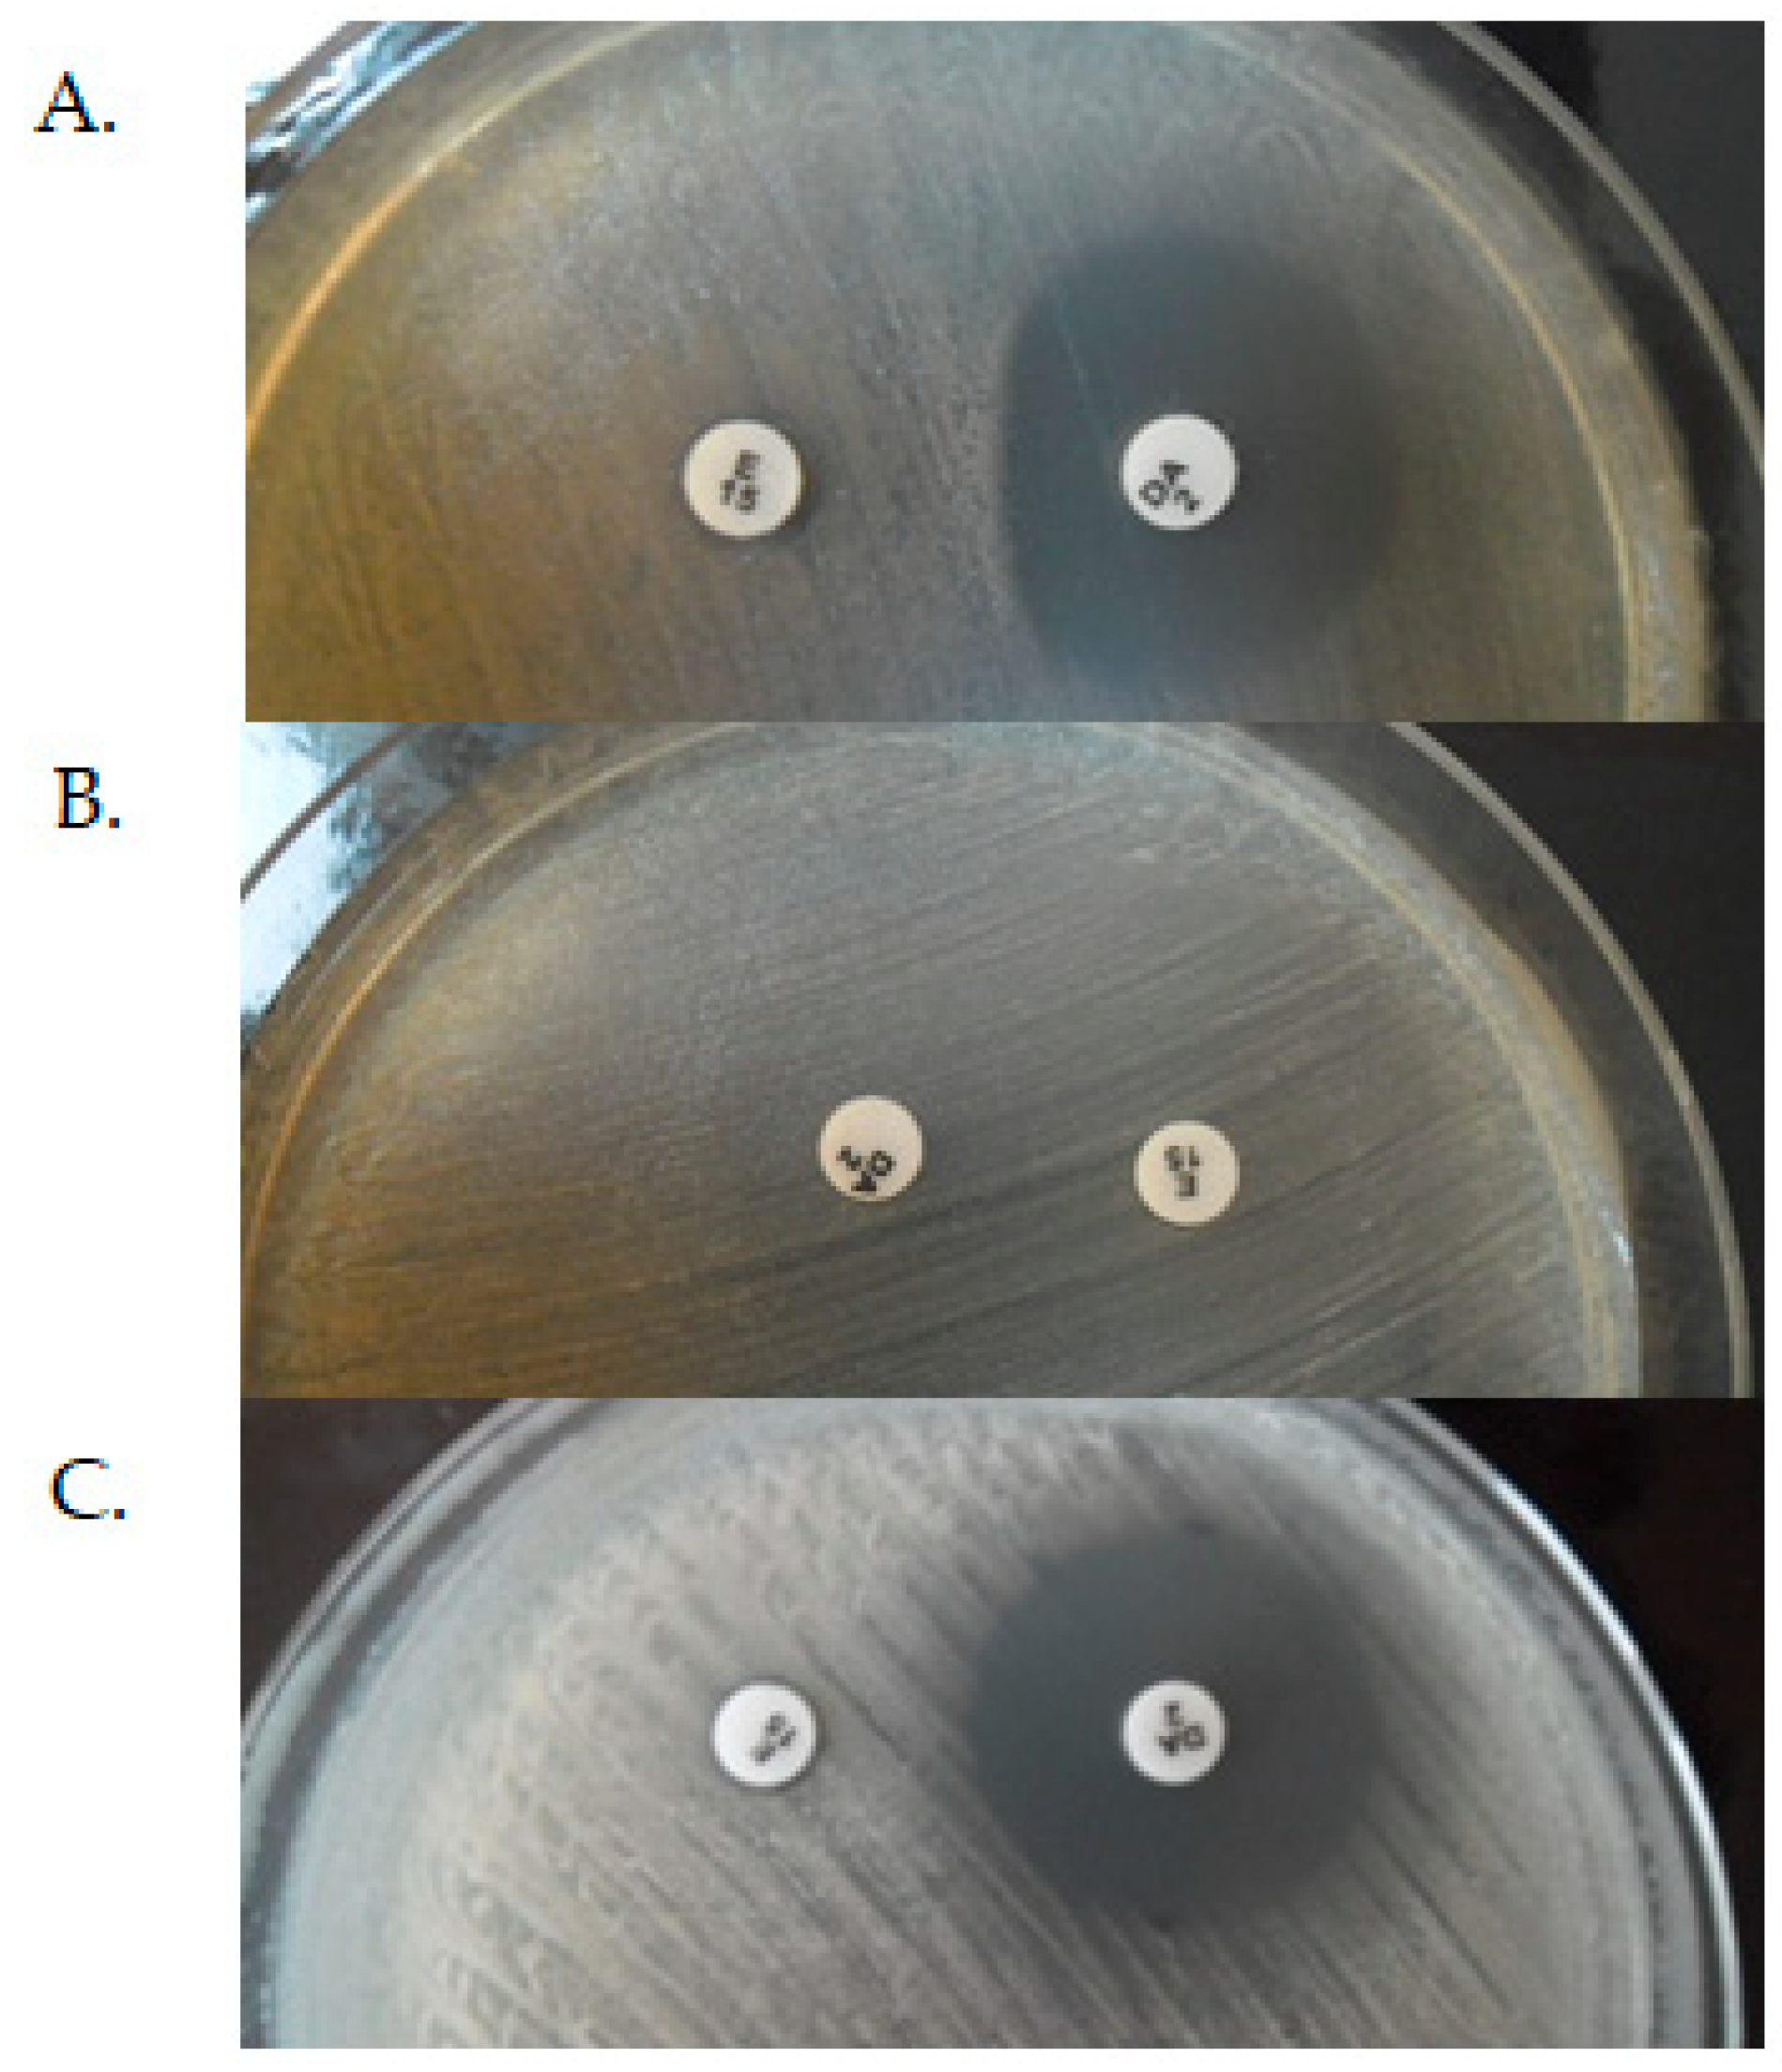
Antibiotics 10 01406 g007

Mechanisms of Resistance to Macrolide Antibiotics among Staphylococcus aureus
Abstract
1. Introduction
2. Macrolide Antibiotics
3. Mechanisms of Resistance to Macrolide Antibiotics
3.1. Modification of the Target Site of Macrolide Action
| MLSB Antibiotic Resistance Phenotype | The Frequency of erm Genes (%) | Localization | Years | References | ||||||||
|---|---|---|---|---|---|---|---|---|---|---|---|---|
| ermA | ermB | ermC | ermA/ermC | ermA/ermB | ermB/ermC | ermA/ermB/ermC | msrA | msrB | ||||
| cMLSB | 14.89 | 11.36 | 74.46 | - | - | - | - | 0 | 0 | Iran | [23] | |
| iMLSB | - | 20.7 | - | - | - | - | - | 51.7 | 20.7 | 2018–2019 | [23] | |
| MSB | - | 10 | - | - | - | - | - | 30 | 20 | [23] | ||
| iMLSB | 15.6 | 3.1 | 18.7 | 4.6 | 0 | 0 | - | - | - | Nepal | 2018 | [22] |
| iMLSB | 3.03 | 3.03 | 21.21 | 15.15 | 9.09 | 21.21 | 27.27 | - | - | Jordan | 2017 | [33] |
| cMLSB | 25.9 | 18.5 | 44.4 | 22.2 | 3.7 | 0 | 14.8 | 0 | 0 | Iran | 2016–2017 | [65] |
| iMLSB | 54.5 | 63.6 | 81.8 | 0 | 0 | 0 | 36.4 | 0 | 0 | [65] | ||
| MSB | 12.5 | 0 | 37.5 | 0 | 0 | 0 | 0 | 0 | 0 | [65] | ||
| not distinguished | 46.7 | - | 36.7 | - | - | - | - | 38.3 | - | Iran | May 2017 | [25] |
| not distinguished | 8.6 | - | 22.9 | 37.1 | - | - | - | 5.7 | - | Iran | 2015–2016 | [27] |
| cMLSB | 13 | - | 19 | 17 | - | - | - | 1 | 0 | Iran | 2016 | [28] |
| iMLSB | 10 | - | 50 | 0 | - | - | - | 10 | 0 | [28] | ||
| MSB | 0 | - | 33 | 11 | - | - | - | 0 | 0 | [28] | ||
| not distinguished | 11 | 3.5 | 20.5 | - | - | - | - | 10.5 | 10.5 | Iran | 2014–2015 | [66] |
| not distinguished | 40.6 | 0 | 17.7 | - | - | - | - | 0 | 0 | Iran | 2014 | [30] |
| iMLSB | 11.1 | 22.2 | 44.4 | - | - | - | - | - | - | Iran | 2010–2012 | [67] |
| not distinguished | 21.6 | 38.7 | 90.1 | - | - | - | - | - | - | China | 2013–2019 | [34] |
| iMLSB | 30.5 | 1 | 69 | - | - | - | - | - | - | China | 2013–2016 | [20] |
| cMLSB | 69.5 | 99 | 31 | - | - | - | - | - | - | [20] | ||
| not distinguished | 59.4 | 8.1 | 24.3 | 16.3 | 5.4 | 2.7 | 2.7 | - | - | China | 2013–2015 | [26] |
| not distinguished | 3.7 | 22.2 | 40.7 | 3.7 | - | 3.7 | - | 0 | 0 | China | 2010–2011 | [29] |
| cMLSB | 16.66 | 54.16 | 0 | 25 | 0 | 4.16 | 0 | - | - | China | - | [68] |
| iMLSB | 0 | 0 | 100 | 0 | 0 | 0 | 0 | - | - | |||
| not distinguished | 39.7 | 0 | 8.7 | 0.6 | 1.2 | 0 | 1.2 | 6.2 | 1.2 | Brazil | 2014–2019 | [32] |
| cMLSB + iMLSB | 9.1 | 0 | 38.6 | 2.3 | - | - | - | - | - | Brazil | 2012 | [31] |
| cMLSB | 90 | 2.5 | 7.5 | 0 | 0 | - | 0 | - | - | Brazil | 2010 | [69] |
| iMLSB | 66.6 | 0 | 33.3 | 0 | 0 | - | 0 | - | - | [69] | ||
| MSB | 0 | 0 | 0 | 0 | 0 | - | 0 | - | - | [69] | ||
| not distinguished | 53.8 | 0 | 30.8 | 7.7 | 0 | 2.6 | - | 5.1 | 0 | Brazil | 2004- 2009 | [37] |
| cMLSBiMLSB | 9.37 | - | 46.87 | 6.25 | - | - | - | 0 | - | [16] | ||
| iMLSB | 17.6 | - | 29.41 | 29.41 | - | - | - | 0 | - | Egypt | 2021 | [16] |
| MSB | - | - | - | - | - | - | - | 100 | - | [16] | ||
| not distinguished | 30.3 | 85 | 99 | 0 | 34 | 85.6 | 22.9 | - | - | Egypt | 2018–2019 | [24] |
| not distinguished | 15.4 | - | 61.5 | - | - | - | - | 23.1 | - | Italy | 2013–2016 | [70] |
| cMLSB | 53.5 | 0.7 | 2.8 | - | - | - | - | - | - | France | 1995 | [21] |
| iMLSB | 9.8 | 0 | 22.2 | - | - | - | - | [21] | ||||
| not distinguished | 0 | 0 | 29.9 | - | - | - | - | - | - | Austria | 2004–2008 | [71] |
| not distinguished | 56.85 | 0 | 25.38 | 1.52 | 0 | 0 | 0 | 5.15 | 0 | Belgium | 2008 | [36] |
| cMLSB | - | - | 28.9 | - | - | - | - | - | - | [4] | ||
| iMLSB | 25.5 | - | 29.4 | - | - | - | - | - | - | Serbia | 2016 | [4] |
| MSB | 0 | 0 | 0 | 0 | 0 | 0 | 0 | 95.6 | 95.6 | [4] | ||
3.2. Resistance Mechanism Related to msr Genes
3.3. Enzymatic Inactivation of Macrolides
3.4. Another Mechanism of Resistance to Macrolides among S. aureus
4. Conclusions
Funding
Institutional Review Board Statement
Informed Consent Statement
Data Availability Statement
Conflicts of Interest
Abbreviations
| A | a-site tRNA |
| ABC | ATP-binding-cassette |
| ABC-f | ATP-binding-cassette family |
| CA-MRSA | community-associated methicillin resistance Staphylococcus aureus |
| CLSI | Clinical and Laboratory Standards Institute |
| cMLSB | constitutive macrolides, lincosamides and streptogramin B phenotype |
| E | e-site tRNA |
| Erm | erythromycin resistance methylase |
| EUCAST | European Committee on Antimicrobial Susceptibility Testing |
| FDA | Food and Drug Administration |
| HA-MRSA | hospital-acquired methicillin resistance Staphylococcus aureus |
| hVISA | heterogeneous vancomycin intermediate-resistance Staphylococcus aureus |
| iMLSB | inductive macrolides, lincosamides, and streptogramin B phenotype |
| LA-MRSA | livestock-associated methicillin resistance Staphylococcus aureus |
| MAC-MRSA | Macrolide-resistant methicillin-resistant Staphylococcus aureus |
| MIC | minimal inhibitory concentration |
| MDR | multi-drug resistance |
| MLSB | macrolides, lincosamides and streptogramin B |
| MSB | phenotype of resistance to macrolides and streptogramin B |
| MRSA | methicillin resistance Staphylococcus aureus |
| MSD | membrane spanning domains |
| MSSA | methicillin sensitive Staphylococcus aureus |
| NBD | nucleotide binding domains |
| NPET | nascent peptide exit tunnel |
| ORF | open reading frame |
| P | p-site tRNA |
| PCT | phenyl transferase center |
| PRSA | penicillin resistance Staphylococcus aureus |
| RBS | ribosome binding site |
| TMD | transmembrane domains |
| WHO | World Health Organization |
| VISA | vancomycin intermediate-resistance Staphylococcus aureus |
| VRSA | vancomycin resistance Staphylococcus aureus |
References
- Duval, R.E.; Grare, M.; Demoré, B. Fight Against Antimicrobial Resistance: We Always Need New Antibacterials but for Right Bacteria. Molecules 2019, 24, 3152. [Google Scholar] [CrossRef]
- Reardon, S. WHO warns against ’post-antibiotic’ era. Nature 2014, 1–2. [Google Scholar] [CrossRef]
- Review on Antimicrobial Resistance. Tackling Drug-Resistant Infections Globally: Final Report and Recommendations. Available online: https://amr-review.org/sites/default/files/160518_Final%20paper_with%20cover.pdf (accessed on 15 August 2019).
- Mišić, M.; Čukić, J.; Vidanovic, D.; Šekler, M.; Matić, S.; Vukašinović, M.; Baskić, D. Prevalence of Genotypes That Determine Resistance of Staphylococci to Macrolides and Lincosamides in Serbia. Front. Public Health 2017, 5, 200. [Google Scholar] [CrossRef]
- Oliveira, D.; Borges, A.; Simões, M. Staphylococcus aureus Toxins and Their Molecular Activity in Infectious Diseases. Toxins 2018, 10, 252. [Google Scholar] [CrossRef]
- Kang, K.; Redner, S. Fluctuation-dominated kinetics in diffusion-controlled reactions. Phys. Rev. A 1985, 32, 435–447. [Google Scholar] [CrossRef]
- Lee, A.S.; De Lencastre, H.; Garau, J.; Kluytmans, J.; Malhotra-Kumar, S.; Peschel, A.; Harbarth, S. Methicillin-resistant Staphylococcus aureus. Nat. Rev. Dis. Prim. 2018, 4, 18033. [Google Scholar] [CrossRef]
- Cespedes, C.; Saïd-Salim, B.; Miller, M.; Lo, S.; Kreiswirth, B.N.; Gordon, R.J.; Vavagiakis, P.; Klein, R.S.; Lowy, F.D. The Clonality ofStaphylococcus aureusNasal Carriage. J. Infect. Dis. 2005, 191, 444–452. [Google Scholar] [CrossRef]
- Lakhundi, S.; Zhang, K. Methicillin-Resistant Staphylococcus aureus: Molecular Characterization, Evolution, and Epidemiology. Clin. Microbiol. Rev. 2018, 31, e00020-18. [Google Scholar] [CrossRef]
- Ghaznavi-Rad, E.; Neela, V.; Shamsudin, M.N.; Moghaddam, H.G.; Tavakol, M.; Van Belkum, A.; Etemadi, M.R.; Andar-Ali, A.F. Diversity in the antimicrobial susceptibility patterns of methicillin-resistant Staphylococcus aureus clones. Eur. J. Clin. Microbiol. Infect. Dis. 2012, 31, 3317–3321. [Google Scholar] [CrossRef]
- Fridkin, S.K.; Hageman, J.C.; Morrison, M.; Sanza, L.T.; Como-Sabetti, K.; Jernigan, J.A.; Harriman, K.; Harrison, L.H.; Lynfield, R.; Farley, M.M. Methicillin-resistant Staphylococcus aureus disease in three communities. N. Engl. J. Med. 2005, 352, 1436–1444. [Google Scholar] [CrossRef]
- McGuinness, W.A.; Malachowa, N.; DeLeo, F.R. Vancomycin Resistance in Staphylococcus aureus. Yale J. Biol. Med. 2017, 90, 269–281. [Google Scholar]
- Shariati, A.; Dadashi, M.; Moghadam, M.T.; Van Belkum, A.; Yaslianifard, S.; Darban-Sarokhalil, D. Global prevalence and distribution of vancomycin resistant, vancomycin intermediate and heterogeneously vancomycin intermediate Staphylococcus aureus clinical isolates: A systematic review and meta-analysis. Sci. Rep. 2020, 10, 1–16. [Google Scholar] [CrossRef]
- Murray, B.E. Vancomycin-Resistant Enterococcal Infections. N. Engl. J. Med. 2000, 342, 710–721. [Google Scholar] [CrossRef]
- Centers for Disease Control and Prevention (CDC). Staphylococcus aureus resistant to vancomycin--United States, 2002. MMWR Morb. Mortal. Wkly. Rep. 2002, 51, 565. [Google Scholar]
- Bishr, A.; Abdelaziz, S.; Yahia, I.; Yassien, M.; Hassouna, N.; Aboshanab, K. Association of Macrolide Resistance Genotypes and Synergistic Antibiotic Combinations for Combating Macrolide-Resistant MRSA Recovered from Hospitalized Patients. Biology 2021, 10, 624. [Google Scholar] [CrossRef]
- Tong, S.Y.C.; Nelson, J.; Paterson, D.L.; Fowler, V.G., Jr.; Howden, B.P.; Cheng, A.C.; Chatfield, M.; Lipman, J.; Van Hal, S.; O’Sullivan, M.; et al. CAMERA2–combination antibiotic therapy for methicillin-resistant Staphylococcus aureus infection: Study protocol for a randomised controlled trial. Trials 2016, 17, 170. [Google Scholar] [CrossRef]
- Bouchiat, C.; El-Zeenni, N.; Chakrakodi, B.; Nagaraj, S.; Arakere, G.; Etienne, J. Epidemiology of Staphylococcus aureus in Bangalore, India: Emergence of the ST217 clone and high rate of resistance to erythromycin and ciprofloxacin in the community. New Microbes New Infect. 2015, 7, 15–20. [Google Scholar] [CrossRef] [PubMed]
- Dinos, G.P. The macrolide antibiotic renaissance. Br. J. Pharmacol. 2017, 174, 2967–2983. [Google Scholar] [CrossRef] [PubMed]
- Yao, W.; Xu, G.; Li, D.; Bai, B.; Wang, H.; Cheng, H.; Zheng, J.; Sun, X.; Lin, Z.; Deng, Q.; et al. Staphylococcus aureus with an erm-mediated constitutive macrolide-lincosamide-streptogramin B resistance phenotype has reduced susceptibility to the new ketolide, solithromycin. BMC Infect. Dis. 2019, 19, 175. [Google Scholar] [CrossRef] [PubMed]
- Lina, G.; Quaglia, A.; Reverdy, M.-E.; Leclercq, R.; Vandenesch, F.; Etienne, J. Distribution of Genes Encoding Resistance to Macrolides, Lincosamides, and Streptogramins among Staphylococci. Antimicrob. Agents Chemother. 1999, 43, 1062–1066. [Google Scholar] [CrossRef]
- Timsina, R.; Shrestha, U.; Singh, A.; Timalsina, B. Inducible clindamycin resistance and erm genes in Staphylococcus aureus in school children in Kathmandu, Nepal. Futur. Sci. OA 2021, 7, FSO361. [Google Scholar] [CrossRef] [PubMed]
- Goudarzi, M.; Tayebi, Z.; Fazeli, M.; Miri, M.; Nasiri, M.J. Molecular Characterization, Drug Resistance and Virulence Analysis of Constitutive and Inducible Clindamycin Resistance Staphylococcus aureus Strains Recovered from Clinical Samples, Tehran—Iran. Infect. Drug Resist. 2020, 13, 1155–1162. [Google Scholar] [CrossRef]
- Kishk, R.M.; Anani, M.M.; Nemr, N.A.; Soliman, N.M.; Fouad, M.M. Inducible clindamycin resistance in clinical isolates of staphylococcus aureus in Suez Canal University Hospital, Ismailia, Egypt. J. Infect. Dev. Ctries. 2020, 14, 1281–1287. [Google Scholar] [CrossRef] [PubMed]
- Khoshnood, S.; Shahi, F.; Jomehzadeh, N.; Montazeri, E.A.; Saki, M.; Mortazavi, S.M.; Maghsoumi-Norouzabad, L. Distribution of genes encoding resistance to macrolides, lincosamides, and streptogramins among methicillin-resistant Staphylococcus aureus strains isolated from burn patients. Acta Microbiol. Immunol. Hung. 2019, 66, 387–398. [Google Scholar] [CrossRef] [PubMed]
- Ding, Y.L.; Fu, J.; Chen, J.; Mo, S.F.; Xu, S.; Lin, N.; Qin, P.; McGrath, E. Molecular characterization and antimicrobial susceptibility of Staphylococcus aureus isolated from children with acute otitis media in Liuzhou, China. BMC Pediatr. 2018, 18, 388. [Google Scholar] [CrossRef]
- Khashei, R.; Malekzadegan, Y.; Ebrahim-Saraie, H.S.; Razavi, Z. Phenotypic and genotypic characterization of macrolide, lincosamide and streptogramin B resistance among clinical isolates of staphylococci in southwest of Iran. BMC Res. Notes 2018, 11, 711. [Google Scholar] [CrossRef] [PubMed]
- Sedaghat, H.; Esfahani, B.N.; Mobasherizadeh, S.; Jazi, A.S.; Halaji, M.; Sadeghi, P.; Emaneini, M.; Havaei, S.A. Phenotypic and genotypic characterization of macrolide resistance among Staphylococcus aureus isolates in Isfahan, Iran. Iran. J. Microbiol. 2017, 9, 264–270. [Google Scholar]
- Liu, X.; Deng, S.; Huang, J.; Huang, Y.; Zhang, Y.; Yanhong, W.; Wang, Y.; Yaling, H.; Sun, C.; Jia, X. Dissemination of macrolides, fusidic acid and mupirocin resistance among Staphylococcus aureus clinical isolates. Oncotarget 2017, 8, 58086–58097. [Google Scholar] [CrossRef][Green Version]
- Moosavian, M.; Shoja, S.; Rostami, S.; Torabipour, M.; Farshadzadeh, Z. Inducible clindamycin resistance in clinical isolates of Staphylococcus aureus due to erm genes, Iran. Iran. J. Microbiol. 2014, 6, 421–427. [Google Scholar]
- Pereira, J.N.D.P.; Rabelo, M.A.; Lima, J.L.D.C.; Neto, A.M.B.; Lopes, A.C.D.S.; Maciel, M.A.V. Phenotypic and molecular characterization of resistance to macrolides, lincosamides and type B streptogramin of clinical isolates of Staphylococcus spp. of a university hospital in Recife, Pernambuco, Brazil. Braz. J. Infect. Dis. 2016, 20, 276–281. [Google Scholar] [CrossRef]
- Rossato, A.M.; Primon-Barros, M.; Rocha, L.D.L.; Reiter, K.C.; Dias, C.A.G.; D’Azevedo, P.A. Resistance profile to antimicrobials agents in methicillin-resistant Staphylococcus aureus isolated from hospitals in South Brazil between 2014–2019. Rev. Soc. Bras. Med. Trop. 2020, 53, e20200431. [Google Scholar] [CrossRef]
- Jarajreh, D.; Aqel, A.; Alzoubi, H.; Al-Zereini, W. Prevalence of inducible clindamycin resistance in methicillin-resistant Staphylococcus aureus: The first study in Jordan. J. Infect. Dev. Ctries. 2017, 11, 350–354. [Google Scholar] [CrossRef][Green Version]
- Li, X.; Huang, T.; Xu, K.; Li, C.; Li, Y. Molecular Characteristics and Virulence Gene Profiles of Staphylococcus Aureus Isolates in Hainan, China. BMC Infect. Dis. 2019, 19, 1–12. [Google Scholar] [CrossRef] [PubMed]
- Sasirekha, B.; Usha, M.S.; Amruta, J.A.; Ankit, S.; Brinda, N.; Divya, R. Incidence of constitutive and inducible clindamycin resistance among hospital-associated Staphylococcus aureus. 3 Biotech 2014, 4, 85–89. [Google Scholar] [CrossRef]
- Vandendriessche, S.; Kadlec, K.; Schwarz, S.; Denis, O. Methicillin-susceptible Staphylococcus aureus ST398-t571 harbouring the macrolide-lincosamide-streptogramin B resistance gene erm(T) in Belgian hospitals. J. Antimicrob. Chemother. 2011, 66, 2455–2459. [Google Scholar] [CrossRef]
- Teodoro, C.R.S.; Mattos, C.S.; Cavalcante, F.S.; Pereira, E.M.; dos Santos, K.R.N. Characterization of MLSb resistance among Staphylococcus aureus and Staphylococcus epidermidis isolates carrying different SCCmec types. Microbiol. Immunol. 2012, 56, 647–650. [Google Scholar] [CrossRef] [PubMed]
- Emeryk, A.; Mazurek, H.; Pirożyński, M. Macrolide antibiotics in respiratory diseases. Recommendations of the Polish Expert Group—AD 2015. Adv. Respir. Med. 2015, 84, 62−80. [Google Scholar] [CrossRef] [PubMed]
- Bethesda: National Institute of Diabetes and Digestive and Kidney Diseases. Clarithromycin. LiverTox 2012. Available online: https://www.ncbi.nlm.nih.gov/books/NBK547886/ (accessed on 4 March 2021).
- Sandman, Z.; Iqbal, O.A. Azithromycin. StatPearls Publishing, 2021. Available online: https://www.ncbi.nlm.nih.gov/books/NBK557766/ (accessed on 4 March 2021).
- Katz, L.; Ashley, G.W. Translation and Protein Synthesis: Macrolides. Chem. Rev. 2005, 105, 499–528. [Google Scholar] [CrossRef]
- Fyfe, C.; Grossman, T.H.; Kerstein, K.; Sutcliffe, J. Resistance to Macrolide Antibiotics in Public Health Pathogens. Health Pathog. 2016, 1–37. [Google Scholar] [CrossRef]
- Bryskier, A. Ketolides—telithromycin, an example of a new class of antibacterial agents. Clin. Microbiol. Infect. 2000, 6, 661–669. [Google Scholar] [CrossRef]
- Georgopapadakou, N.H. The wobbly status of ketolides: Where do we stand? Expert Opin. Investig. Drugs 2014, 23, 1313–1319. [Google Scholar] [CrossRef] [PubMed]
- Seiple, I.B.; Zhang, Z.; Jakubec, P.; Langlois-Mercier, A.; Wright, P.M.; Hog, D.T.; Yabu, K.; Allu, S.R.; Fukuzaki, T.; Carlsen, P.N.; et al. A platform for the discovery of new macrolide antibiotics. Nature 2016, 533, 338–345. [Google Scholar] [CrossRef] [PubMed]
- Pavlova, A.; Parks, J.M.; Oyelere, A.K.; Gumbart, J.C. Toward the rational design of macrolide antibiotics to combat resistance. Chem. Biol. Drug Des. 2017, 90, 641–652. [Google Scholar] [CrossRef]
- Vázquez-Laslop, N.; Mankin, A.S. How Macrolide Antibiotics Work. Trends Biochem. Sci. 2018, 43, 668–684. [Google Scholar] [CrossRef]
- Leclercq, R. Mechanisms of Resistance to Macrolides and Lincosamides: Nature of the Resistance Elements and Their Clinical Implications. Clin. Infect. Dis. 2002, 34, 482–492. [Google Scholar] [CrossRef] [PubMed]
- van Hoek, A.H.A.M.; Mevius, D.; Guerra, B.; Mullany, P.; Roberts, A.P.; Aarts, H.J.M. Acquired Antibiotic Resistance Genes: An Overview. Front. Microbiol. 2011, 2, 203. [Google Scholar] [CrossRef] [PubMed]
- Feßler, A.T.; Wang, Y.; Wu, C.; Schwarz, S. Mobile macrolide resistance genes in staphylococci. Plasmid 2018, 99, 2–10. [Google Scholar] [CrossRef]
- Skarżyńska, M.; Zając, M.; Wasyl, D. Antibiotics and bacteria: Mechanisms of action and resistance strategies. Adv. Microbiol. 2020, 59, 49–62. [Google Scholar] [CrossRef]
- Svetlov, M.S.; Syroegin, E.A.; Aleksandrova, E.V.; Atkinson, G.C.; Gregory, S.T.; Mankin, A.S.; Polikanov, Y.S. Structure of Erm-modified 70S ribosome reveals the mechanism of macrolide resistance. Nat. Chem. Biol. 2021, 17, 412–420. [Google Scholar] [CrossRef]
- Ramos, G.G.; Xiong, L.; Zhong, P.; Mankin, A. Binding Site of Macrolide Antibiotics on the Ribosome: New Resistance Mutation Identifies a Specific Interaction of Ketolides with rRNA. J. Bacteriol. 2001, 183, 6898–6907. [Google Scholar] [CrossRef]
- Liu, M.; Douthwaite, S. Activity of the Ketolide Telithromycin Is Refractory to Erm Monomethylation of Bacterial rRNA. Antimicrob. Agents Chemother. 2002, 46, 1629–1633. [Google Scholar] [CrossRef]
- Daurel, C.; Huet, C.; Dhalluin, A.; Bes, M.; Etienne, J.; Leclercq, R. Differences in Potential for Selection of Clindamycin-Resistant Mutants Between Inducible erm (A) and erm (C) Staphylococcus aureus Genes. J. Clin. Microbiol. 2008, 46, 546–550. [Google Scholar] [CrossRef] [PubMed]
- Alekshun, M.N.; Levy, S.B. Molecular Mechanisms of Antibacterial Multidrug Resistance. Cell 2007, 128, 1037–1050. [Google Scholar] [CrossRef]
- Schmitz, F.-J.; Petridou, J.; Jagusch, H.; Astfalk, N.; Scheuring, S.; Schwarz, S. Molecular characterization of ketolide-resistant erm(A)-carrying Staphylococcus aureus isolates selected in vitro by telithromycin, ABT-773, quinupristin and clindamycin. J. Antimicrob. Chemother. 2002, 49, 611–617. [Google Scholar] [CrossRef][Green Version]
- Gupta, P.; Kannan, K.; Mankin, A.S.; Vázquez-Laslop, N. Regulation of Gene Expression by Macrolide-Induced Ribosomal Frameshifting. Mol. Cell 2013, 52, 629–642. [Google Scholar] [CrossRef] [PubMed]
- Ramu, H.; Mankin, A.; Vazquez-Laslop, N. Programmed drug-dependent ribosome stalling. Mol. Microbiol. 2009, 71, 811–824. [Google Scholar] [CrossRef]
- European Committee on Antimicrobial Susceptibility Testing. Breakpoint Tables for Interpretation of MICs and Zone Diameters. Version 11.0. January 2021. Available online: https://www.eucast.org/fileadmin/src/media/PDFs/EUCAST_files/Breakpoint_tables/v_11.0_Breakpoint_Tables.pdf (accessed on 1 January 2021).
- Wolter, N.; Smith, A.M.; Farrell, D.J.; Northwood, J.B.; Douthwaite, S.; Klugman, K.P. Telithromycin Resistance in Streptococcus pneumoniae Is Conferred by a Deletion in the Leader Sequence of erm (B) That Increases rRNA Methylation. Antimicrob. Agents Chemother. 2008, 52, 435–440. [Google Scholar] [CrossRef] [PubMed][Green Version]
- Drinkovic, D.; Fuller, E.R.; Shore, K.P.; Holland, D.J.; Ellis-Pegler, R. Clindamycin treatment of Staphylococcus aureus ex-pressing inducible clindamycin resistance. J. Antimicrob. Chemother. 2001, 48, 315–316. [Google Scholar] [CrossRef] [PubMed]
- Frank, A.L.; Marcinak, J.F.; Mangat, P.D.; Tjhio, J.T.; Kelkar, S.; Schreckenberger, P.C.; Quinn, J.P. Clindamycin treatment of methicillin-resistant Staphylococcus aureus infections in children. Pediatr. Infect. Dis. J. 2002, 21, 530–534. [Google Scholar] [CrossRef]
- Siberry, G.K.; Tekle, T.; Carroll, K.; Dick, J. Failure of Clindamycin Treatment of Methicillin-Resistant Staphylococcus aureus Expressing Inducible Clindamycin Resistance In Vitro. Clin. Infect. Dis. 2003, 37, 1257–1260. [Google Scholar] [CrossRef]
- Khodabandeh, M.; Mohammadi, M.; Abdolsalehi, M.R.; Alvandimanesh, A.; Gholami, M.; Bibalan, M.H.; Pournajaf, A.; Kafshgari, R.; Rajabnia, R. Analysis of Resistance to Macrolide–Lincosamide–Streptogramin B Among mecA-Positive Staphylococcus Aureus Isolates. Osong Public Health Res. Perspect. 2019, 10, 25–31. [Google Scholar] [CrossRef] [PubMed]
- Fasihi, Y.; Saffari, F.; Ghahraman, M.R.K.; Kalantar-Neyestanaki, D. Molecular Detection of Macrolide and Lincosamide-Resistance Genes in Clinical Methicillin-Resistant Staphylococcus aureus Isolates from Kerman, Iran. Arch. Pediatr. Infect. Dis. 2016, 5, 4–8. [Google Scholar] [CrossRef]
- Havaei, S.A.; Ghanbari, F.; Ghajavand, H.; Havaei, R.; Jami, M.-S.; Khademi, F.; Heydari, L.; Shahin, M. Distribution of erm genes among Staphylococcus aureus isolates with inducible resistance to clindamycin in Isfahan, Iran. Adv. Biomed. Res. 2016, 5, 62. [Google Scholar] [CrossRef]
- Chen, X.; Sun, K.; Dong, D.; Luo, Q.; Peng, Y.; Chen, F. Antimicrobial Resistance and Molecular Characteristics of Nasal Staphylococcus aureus Isolates from Newly Admitted Inpatients. Ann. Lab. Med. 2016, 36, 250–254. [Google Scholar] [CrossRef][Green Version]
- Coutinho, V.D.L.S.; Paiva, R.M.; Reiter, K.C.; De-Paris, F.; Barth, A.L.; Machado, A.B.M.P. Distribution of erm genes and low prevalence of inducible resistance to clindamycin among staphylococci isolates. Braz. J. Infect. Dis. 2010, 14, 564–568. [Google Scholar] [CrossRef][Green Version]
- Cabrera, R.; Fernández-Barat, L.; Motos, A.; López-Aladid, R.; Vázquez, N.; Panigada, M.; Álvarez-Lerma, F.; López, Y.; Muñoz, L.; Castro, P.; et al. Molecular characterization of methicillin-resistant Staphylococcus aureus clinical strains from the endotracheal tubes of patients with nosocomial pneumonia. Antimicrob. Resist. Infect. Control. 2020, 9, 10–43. [Google Scholar] [CrossRef] [PubMed]
- Zarfel, G.; Krziwanek, K.; Johler, S.; Hoenigl, M.; Leitner, E.; Kittinger, C.; Masoud, L.; Feierl, G.; Grisold, A.J. Virulence and antimicrobial resistance genes in human MRSA ST398 isolates in Austria. Epidemiol. Infect. 2013, 141, 888–892. [Google Scholar] [CrossRef]
- Mlynarczyk, A.; Mlynarczyk, G. Molecular Mechanisms of Resistance to Antibacterial Drugs in Staphylococcus Aureus. Post. Mikrobiol. 2008, 47, 423–429. [Google Scholar]
- Partridge, S.R.; Kwong, S.M.; Firth, N.; Jensen, S.O. Mobile Genetic Elements Associated with Antimicrobial Resistance. Clin. Microbiol. Rev. 2018, 31, e00088-17. [Google Scholar] [CrossRef]
- Arenz, S.; Wilson, D. Bacterial Protein Synthesis as a Target for Antibiotic Inhibition. Cold Spring Harb. Perspect. Med. 2016, 6, a025361. [Google Scholar] [CrossRef] [PubMed]
- Ojo, K.K.; Striplin, M.J.; Ulep, C.C.; Close, N.S.; Zittle, J.; Luis, H.; Bernardo, M.; Leitao, J.; Roberts, M.C. Staphylococcus Efflux msr (A) Gene Characterized in Streptococcus, Enterococcus, Corynebacterium, and Pseudomonas Isolates. Antimicrob. Agents Chemother. 2006, 50, 1089–1091. [Google Scholar] [CrossRef]
- Sharkey, L.; Edwards, T.; O’Neill, A.J. ABC-F Proteins Mediate Antibiotic Resistance through Ribosomal Protection. mBio 2016, 7, e01975-15. [Google Scholar] [CrossRef]
- Reynolds, E.; Ross, J.I.; Cove, J.H. Msr(A) and related macrolide/streptogramin resistance determinants: Incomplete trans-porters? J. Antimicrob. Agents 2003, 22, 228–236. [Google Scholar] [CrossRef]
- Lage, H. ABC-transporters: Implications on drug resistance from microorganisms to human cancers. Int. J. Antimicrob. Agents 2003, 22, 188–199. [Google Scholar] [CrossRef]
- Nunez-Samudio, V.; Chesneau, O. Functional interplay between the ATP binding cassette Msr(D) protein and the membrane facilitator superfamily Mef(E) transporter for macrolide resistance in Escherichia coli. Res. Microbiol. 2013, 164, 226–235. [Google Scholar] [CrossRef] [PubMed]
- Chen, Z.; Shi, T.; Zhang, L.; Zhu, P.; Deng, M.; Huang, C.; Hu, T.; Jiang, L.; Li, J. Mammalian drug efflux transporters of the ATP binding cassette (ABC) family in multidrug resistance: A review of the past decade. Cancer Lett. 2016, 370, 153–164. [Google Scholar] [CrossRef]
- Morar, M.; Pengelly, K.; Koteva, K.; Wright, G.D. Mechanism and Diversity of the Erythromycin Esterase Family of Enzymes. Biochemistry 2012, 51, 1740–1751. [Google Scholar] [CrossRef]
- Chesneau, O.; Tsvetkova, K.; Courvalin, P. Resistance phenotypes conferred by macrolide phosphotransferases. FEMS Microbiol. Lett. 2007, 269, 317–322. [Google Scholar] [CrossRef] [PubMed]
- Lenart-Boroń, A.; Wolny-Koładka, K.; Juraszek, K.; Kasprowicz, A. Phenotypic and molecular assessment of antimicrobial resistance profile of airborne Staphylococcus spp. isolated from flats in Kraków. Aerobiologia 2017, 33, 435–444. [Google Scholar] [CrossRef] [PubMed]
- Bouter, A.; Leclercq, R.; Cattoir, V. Molecular basis of resistance to macrolides, lincosamides and streptogramins in Staphy-lococcus saprophyticus clinical isolates. Int. J. Antimicrob. Agents 2011, 37, 118–123. [Google Scholar] [CrossRef][Green Version]
- Schwendener, S.; Donà, V.; Perreten, V. The Novel Macrolide Resistance Genes mef (D), msr (F), and msr (H) Are Present on Resistance Islands in Macrococcus canis, Macrococcus caseolyticus, and Staphylococcus aureus. Antimicrob. Agents Chemother. 2020, 64, 00160-20. [Google Scholar] [CrossRef] [PubMed]

| Phenotype of Resistance to Methicillin | The Prevalence of cMLSB, iMLSB and MSB Phenotypes (%) | References | ||
|---|---|---|---|---|
| cMLSB | iMLSB | MSB | ||
| MRSA | 73.7 | 18.4 | 7.9 | [16] |
| MSSA | 26.7 | 66.6 | 6.7 | |
| MRSA | 83 | - | - | [21] |
| MSSA | - | 82 | - | |
| MRSA | - | 76.4 | - | [22] |
| MSSA | 0 | 4.2 | 0 | |
| MRSA | 30.2 | 33.8 | 11.6 | [23] |
| MSSA | 24.4 | 0 | 0 | |
| MRSA | 51.89 | 18.5 | 0 | [24] |
| MSSA | 17.6 | 5.9 | 5.9 | |
| MRSA | 0 | 20 | 0 | [26] |
| MSSA | 0 | 16 | 0 | |
| MRSA | 84.3 | 6.25 | 9.375 | [27] |
| MSSA | 66.66 | 33.33 | 0 | |
| MRSA | - | - | - | [28] |
| MSSA | 69 | 5.4 | 1.8 | |
| MRSA | 68.2 | 4.5 | 4.5 | [31] |
| MSSA | 10.8 | 10.8 | 5.4 | |
| MRSA | 46.1 | 7.4 | 26.3 | [32] |
| MSSA | - | - | - | |
| MRSA | 18.6 | 33 | 4.7 | [33] |
| MSSA | - | - | - | |
| MRSA | 5.22 | 0.65 | 5.88 | [35] |
| MSSA | 7.84 | 8.49 | 13.07 | |
| Phenotype of Resistance to Methicillin | The Prevalence of erm Genes (%) | References | ||
|---|---|---|---|---|
| ermA | ermB | ermC | ||
| MRSA | 57.6 | 0 | 4.9 | [21] |
| MSSA | 5.6 | 0.7 | 20.1 | |
| MRSA | 58.8 | 11.7 | 70.5 | [22] |
| MSSA | 4.2 | 0 | 0 | |
| MRSA | 7.69 | 13.84 | 27.69 | [23] |
| MSSA | 9.6 | 14.3 | 80.9 | |
| MRSA | 18.5 | 55.6 | 51.9 | [24] |
| MSSA | 11.8 | 29.4 | 47.1 | |
| MRSA | 46.7 | 0 | 36.7 | [25] |
| MSSA | - | - | - | |
| MRSA | 83.3 | 16.7 | 41.7 | [26] |
| MSSA | 32.4 | 2.7 | 10.8 | |
| MRSA | 62.5 | 0 | 84.375 | [27] |
| MSSA | 0 | 0 | 66.66 | |
| MRSA | 19 | 0 | 30 | [28] |
| MSSA | 9 | 0 | 33 | |
| MRSA | 16.7 | 0 | 66.7 | [29] |
| MSSA | 9.5 | 33.3 | 47.6 | |
| MRSA | 39.5 | 0 | 16.9 | [30] |
| MSSA | 1.6 | 0 | 0.8 | |
| MRSA | 51.6 | 57.57 | 84.84 | [33] |
| MSSA | - | - | - | |
| MRSA | 11.1 | 38.9 | 87 | [34] |
| MSSA | 11.1 | 38.9 | 87 | |
| MRSA | 35.66 | 0 | 13.05 | [36] |
| MSSA | 8.01 | 0 | 4.24 | |
| MRSA | 53.8 | 0 | 30.8 | [37] |
| MSSA | - | - | - | |
Publisher’s Note: MDPI stays neutral with regard to jurisdictional claims in published maps and institutional affiliations. |
© 2021 by the author. Licensee MDPI, Basel, Switzerland. This article is an open access article distributed under the terms and conditions of the Creative Commons Attribution (CC BY) license (https://creativecommons.org/licenses/by/4.0/).
Share and Cite
Miklasińska-Majdanik, M. Mechanisms of Resistance to Macrolide Antibiotics among Staphylococcus aureus. Antibiotics 2021, 10, 1406. https://doi.org/10.3390/antibiotics10111406
Miklasińska-Majdanik M. Mechanisms of Resistance to Macrolide Antibiotics among Staphylococcus aureus. Antibiotics. 2021; 10(11):1406. https://doi.org/10.3390/antibiotics10111406
Chicago/Turabian StyleMiklasińska-Majdanik, Maria. 2021. "Mechanisms of Resistance to Macrolide Antibiotics among Staphylococcus aureus" Antibiotics 10, no. 11: 1406. https://doi.org/10.3390/antibiotics10111406
APA StyleMiklasińska-Majdanik, M. (2021). Mechanisms of Resistance to Macrolide Antibiotics among Staphylococcus aureus. Antibiotics, 10(11), 1406. https://doi.org/10.3390/antibiotics10111406

